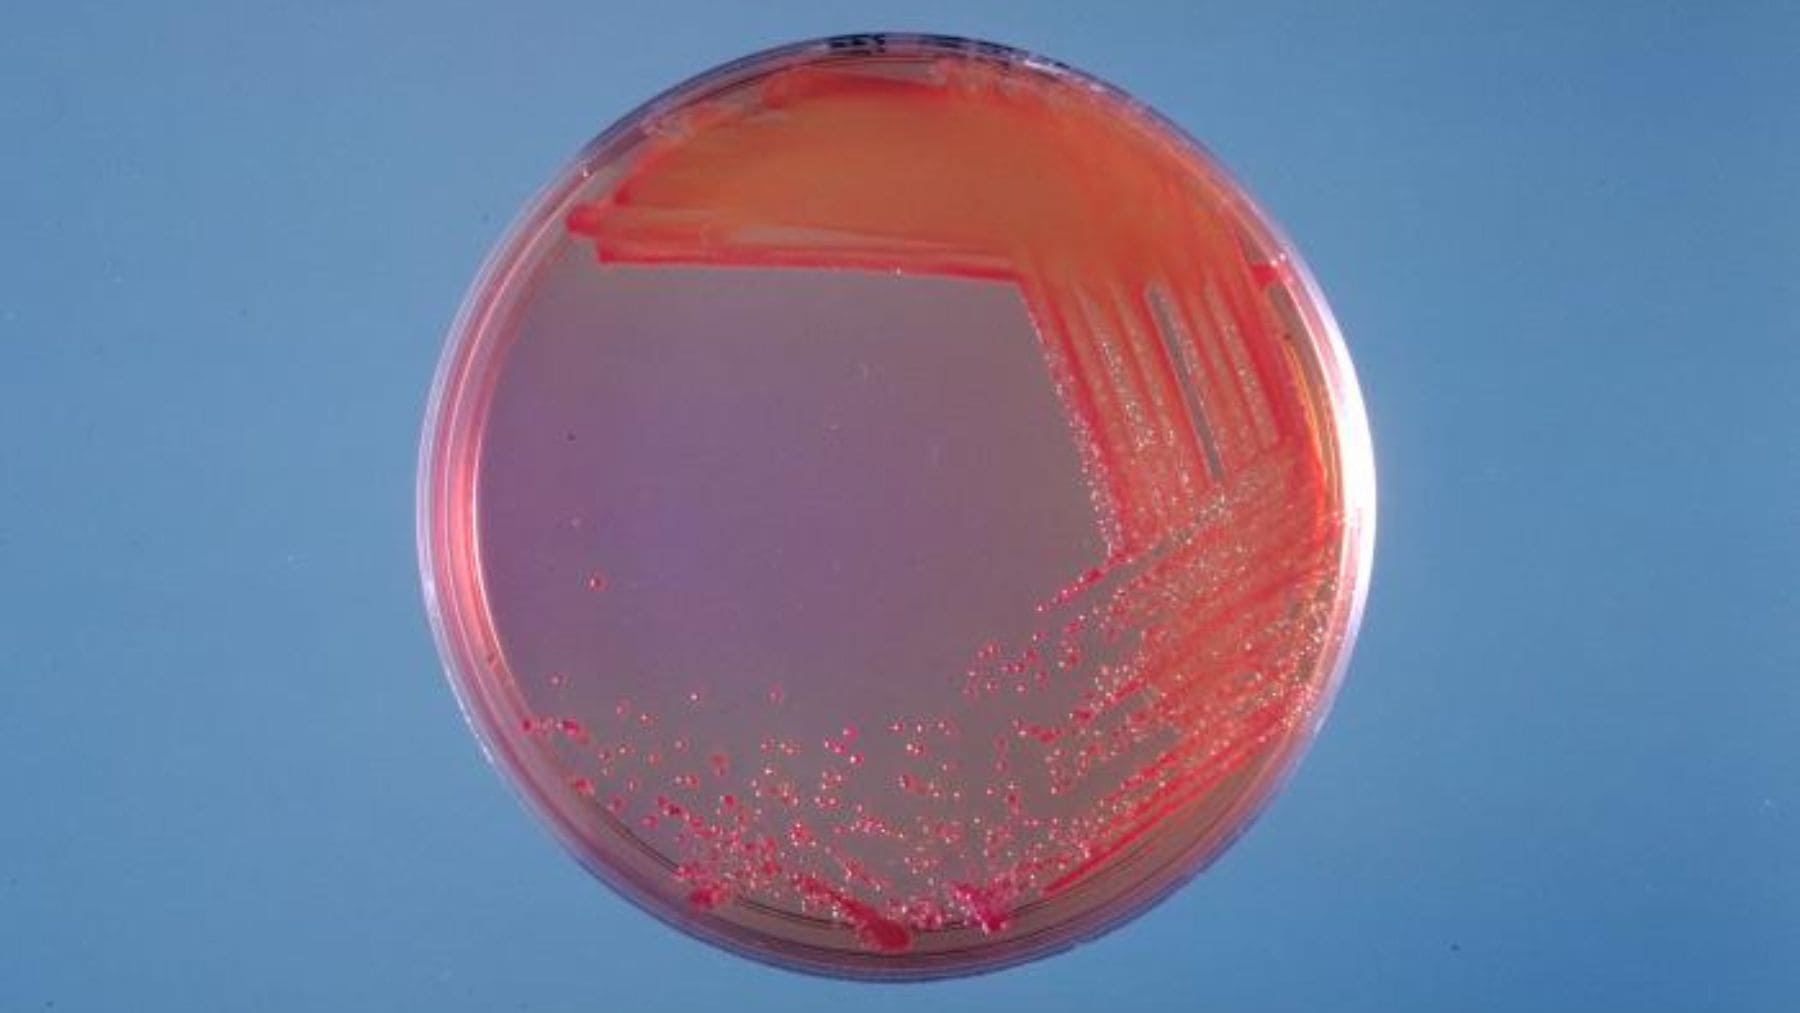
Placa de Petri con bacterias resistentes a antibióticos tras exposición a desinfectantes en laboratorio.

En los hospitales la limpieza es una rutina que protege a pacientes muy frágiles. Por eso llama la atención que un producto pensado para frenar infecciones pueda, en ciertas condiciones, dar ventaja a algunos microbios.
Un estudio ha observado que trazas de clorhexidina, un antiséptico habitual, pueden quedarse en superficies más de 24 horas y exponer a las bacterias a dosis demasiado bajas para matarlas. En esa “zona gris”, algunas aprenden a tolerar mejor el químico y, además, podrían acabar moviéndose por el aire sobre partículas invisibles.
Un antiséptico muy usado
La clorhexidina aparece en muchos protocolos sanitarios y se utiliza desde hace décadas en la práctica clínica. Se aplica, por ejemplo, para preparar la piel antes de una cirugía o la inserción de un catéter, y también en la higiene de pacientes en unidades de cuidados intensivos, además de otras tareas de esterilización.
La investigadora Erica Hartmann (Northwestern University) insiste en que no hablamos de “demonizar” el producto. “Se usa en entornos donde los pacientes son increíblemente vulnerables” y es importante para mantenerlos a salvo, subraya en la nota del equipo.
Restos que duran más de un día
La primera parte del trabajo se hizo en laboratorio, simulando tareas habituales de limpieza. El equipo aplicó clorhexidina sobre materiales comunes (plástico, metal y laminado) y luego limpió esas superficies con productos sin clorhexidina, como los usados de forma rutinaria en hospitales.
Incluso tras esa limpieza, la clorhexidina seguía detectable pasadas 24 horas. Los niveles eran demasiado bajos para matar bacterias, pero lo bastante altos como para exponerlas de manera continuada a pequeñas dosis.
Para ver qué ocurre con esas “sobras” de químico, los investigadores expusieron bacterias relevantes en clínica, como Escherichia coli, a concentraciones traza. Tras un día completo, los microbios seguían vivos, lo que apunta a un riesgo muy concreto (exposición repetida a dosis subletales) y no a un fallo del producto cuando se usa bien.
El lavabo como punto caliente
La segunda parte del estudio miró el entorno real de una unidad de cuidados intensivos médicos (MICU). El equipo recogió casi 200 muestras de superficies como barandillas de camas, teclados, interruptores, marcos superiores de puertas y, sobre todo, desagües de lavabos.
A partir de ahí aislaron más de 1.400 bacterias y hallaron que alrededor del 36% mostraba algún nivel de tolerancia a la clorhexidina. Los desagües destacaron como el mayor “punto caliente” y la nota apunta a un detalle técnico que explica por qué (el sifón en forma de U bajo el lavabo, que retiene agua y humedad).
Hartmann lo resume con una imagen fácil de entender. “Cada vez que corre el agua, se generan aerosoles”, y esas gotitas pueden favorecer que parte de esa carga microbiana se disperse por la habitación.
Cuando las bacterias se suben al polvo
El hallazgo más inesperado fue encontrar bacterias con signos de tolerancia en la parte superior de los marcos de puerta. Es una zona que casi nadie toca, y por eso el equipo la incluyó como “control negativo”, esperando que saliera limpia.
Que aparecieran allí sugiere un transporte por el aire. La explicación que plantean es sencilla y un poco inquietante (bacterias que viajan pegadas a partículas en suspensión, como células de piel muerta) y el polvo acumulado en zonas altas actuando como “atrapa todo”.
Tolerancia no es resistencia
Conviene poner nombres, porque no es lo mismo. La tolerancia describe a bacterias que aguantan mejor ciertos niveles de un químico, pero que todavía pueden eliminarse cuando el antiséptico se usa en la concentración adecuada, mientras que la resistencia implica que pueden crecer incluso ante dosis que normalmente las frenarían.
El trabajo añade otro matiz, porque estas exposiciones a trazas podrían favorecer intercambios de ADN entre bacterias (por ejemplo mediante plásmidos) y algunos de esos genes se han relacionado con resistencias a antibióticos, según se explica en la cobertura del estudio.
Qué significa esto para la vida diaria
En casa es fácil caer en el “por si acaso” con sprays o toallitas “antibacterianas”. Pero, ¿de verdad hace falta desinfectar cada día una mesa que solo ha visto migas de pan? Hartmann recuerda que, salvo que haya una persona enferma o inmunodeprimida, “el entorno alrededor no necesita ser desinfectado” y lo sensato es tirar de jabón y agua.
Además, la resistencia a los antimicrobianos ya es un problema enorme. La Organización Mundial de la Salud estima que la resistencia bacteriana estuvo directamente detrás de 1,27 millones de muertes en 2019 y contribuyó a 4,95 millones de fallecimientos en todo el mundo, así que cada presión innecesaria sobre los microbios cuenta. Y eso se nota.
Un debate que también es ambiental
La resistencia no depende solo de recetas médicas. También tiene que ver con el uso de sustancias antimicrobianas en distintos espacios y con las rutas por las que estos productos pueden acabar entrando en el entorno, un aspecto que cada vez se mira más desde la salud pública y la gestión ambiental.
Por eso, informes públicos como el de la Environment Agency del Reino Unido revisan qué se sabe sobre desinfectantes y resistencia, precisamente para entender mejor riesgos y vacíos de información. La clave no es dejar de limpiar, sino hacerlo con cabeza y con el producto adecuado para cada situación.
En el fondo, el mensaje suena simple, pero cuesta aplicarlo. Usar bien estos productos en el hospital es crucial y nadie lo discute, pero fuera de ahí conviene preguntarse si estamos limpiando o “desinfectando por rutina”. Y esa diferencia, a largo plazo, puede pasar factura.
El estudio ha sido publicado en la revista Environmental Science & Technology.